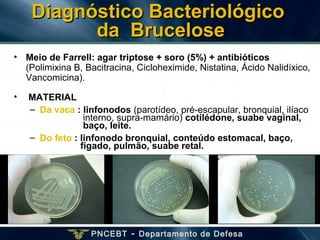
PNCEBT - Departamento de Defesa
Diagnóstico BacteriológicoDiagnóstico Bacteriológico
da Bruceloseda Brucelose
• Meio de Farrell: agar triptose + soro (5%) + antibióticos
(Polimixina B, Bacitracina, Cicloheximide, Nistatina, Ácido Nalidíxico,
Vancomicina).
• MATERIAL
– Da vaca : linfonodos (parotídeo, pré-escapular, bronquial, ilíaco
interno, supra-mamário) cotilédone, suabe vaginal,
baço, leite.
– Do feto : linfonodo bronquial, conteúdo estomacal, baço,
fígado, pulmão, suabe retal.

O documento descreve o Programa Nacional de Controle e Erradicação da Brucelose e da Tuberculose Animal (PNCEBT) no Brasil, fornecendo informações sobre a brucelose bovina, incluindo sua definição, agente causador, epidemiologia, transmissão, sinais clínicos, diagnóstico e controle.